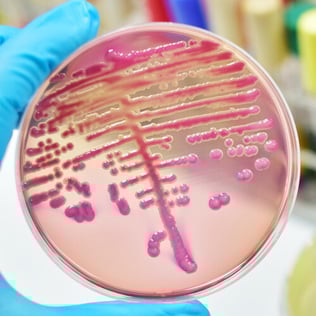
Mycoplasma Contamination
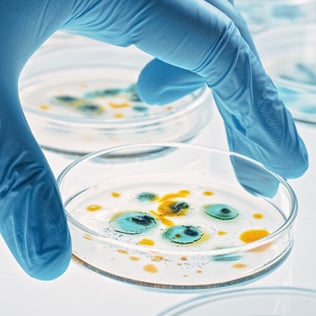
Handling of Cells

Cell Culture Solutions
Media | Reagents | Plasticware
Optimize your Cell Culture workflow with Whitehead Scientific

▶️ Affordable and reliable supply you can count on
▶️ High-quality media: DMEM, RPMI, MEM, HAMS, and more
▶️ Essential reagents: L-Glutamine, Trypsin, Penicillin/Streptomycin, Fetal Bovine Serum (FBS), and more
▶️ Tissue culture plastics: flasks, dishes, plates, and other essentials
▶️ Get expert advice for your lab
Cell Culture Media
Capricorn’s high quality liquid media provides essential nutrients for a wide range of cell culture applications. Each medium is crafted using either the original formula or carefully optimized modifications to ensure consistent performance and stability. With Capricorn media, you can trust in optimal cell growth and dependable results.
▶️ Classical Liquid Media▶️ Classical Powder Media
▶️ Cryopreservation
▶️ Special Media


Cell Culture Reagents
Capricorn’s reagents and supplements enable you to precisely adjust the growth conditions of your cell culture system. Every product undergoes rigorous testing to ensure reproducibility and top-tier performance for your applications.
▶️ Amino Acids▶️ Antibiotics
▶️ Cell Detachment
▶️ Cell Separation
Cell Culture Plasticware
NEST provides premium tissue culture plasticware for all your essential needs. Explore our high quality range for reliable tools to support your cell culture work:
▶️ Dishes▶️ Flasks
▶️ Plates
▶️ Cell Culture Inserts
▶️ Cell Culture System
▶️ Cell Scraper
▶️ Cell Strainer
▶️ Media Bottles
▶️ Tubes

Fetal Bovine Serum (FBS)
Capricorn Scientific’s Gamma Irradiated Fetal Bovine Serum (FBS) is tailored for biopharmaceutical applications such as virus and vaccine production. Our gentle gamma irradiation process maximizes contaminant inactivation without compromising serum quality.

-
Gentle Gamma Irradiation: Innovative method in small-sized boxes achieves optimal irradiation (25-35 kGy), preserving essential nutrients and growth-promoting factors
-
Essential for Cell Culture: Provides amino acids, lipids, sugars, and hormones critical for cell proliferation and viability
-
Sourced and Controlled: Carefully sourced from South America and rigorously quality-controlled to reliably support most cell lines